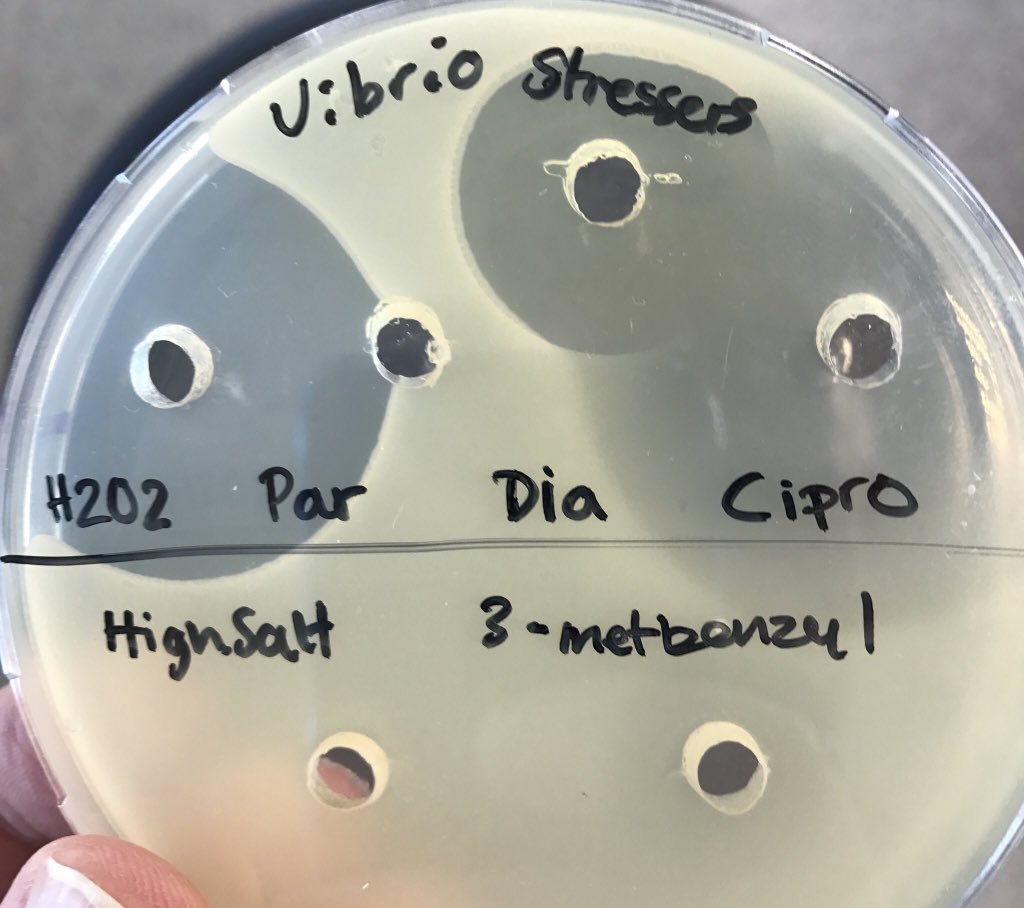

Ida Lauritsen
@lauritsen_i
ID: 899917151984902144
22-08-2017 08:52:23
9 Tweet
85 Followers
238 Following


Congratulations to our very own Ida Lauritsen, Postdoc at DTU Biosustain, who last Friday was awarded with DTUs 'Young Researchers Award' along with 5 other Phd candidates 👏🏼🧬🥳 Read more: bit.ly/37sKyFr #PhD #Biology

Universal method to remove cloning plasmids in bacteria #CRISPR pFREE your cells rdcu.be/uF8V Andreas Porse